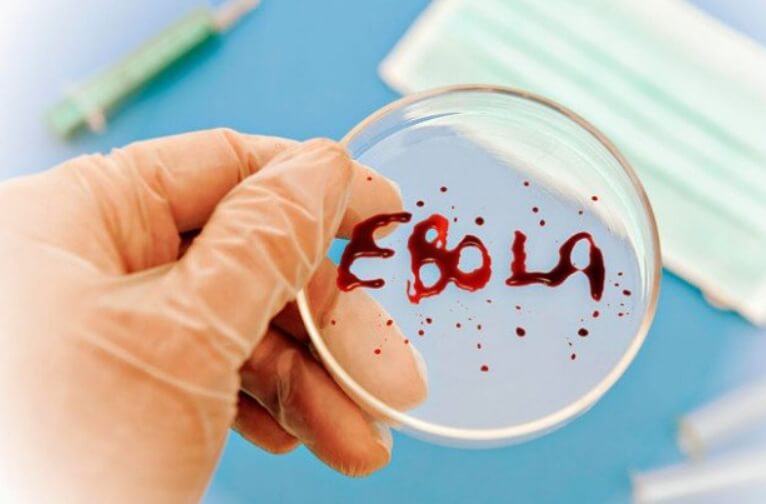
Лихорадку Ласса легко спутать с другими заболеваниями. Фото.

На днях в Великобритании были зафиксированы случаи заражения лихорадкой Ласса. Это стало довольно неожиданной новостью, потому что данное заболевание обычно встречается только на территории Западной Африки. Расследование показало, что заболевшими людьми оказались члены одной семьи, которые как раз вернулись из Африки. Один из заболевших успешно выздоровел, однако другой скончался, даже несмотря на назначенное лечение. Вакцины от лихорадки Ласса не существует, но заболевание считается очень опасным для человеческого организма. На данный момент власти Великобритании занимаются расследованием других вероятных случаев заболевания. Возникает ряд вопросов: существует ли риск распространения лихорадки Ласса по всему миру, как она разрушает организм и через что передается? У ученых уже есть ответы.

Возбудителями лихорадки Ласса являются грызуны
Открытие лихорадки Ласса
Болезнь впервые была описана в 1950-е годы, но ее возбудитель был найден только в 1969 году, во время изучения зараженного человека из нигерийского города Ласса. Вирус называется Lassa mammarenavirus и размножается внутри грызунов. Вирус имеет сферическую форму и обладает оболочкой, на поверхности которой имеются ворсинки диаметром до 150 нанометров. Как правило, резервуарами для развития вируса являются многососковые крысы вида Mastomys. Сами они не страдают от болезни, но распространяют вирус через мочу и помет. Также вирус хорошо себя чувствует и размножается в почках зеленой мартышки (Chlorocebus sabaeus).

Возбудитель болезни Ласса под микроскопом
Как заражаются лихорадкой Ласса?
В группу риска входят жители деревень, потому что следы мочи и помета зараженных животных обычно встречаются именно там. Сегодня заболевание распространено в Бенине, Гвинее, Гане, Либерии и других странах Западной Африки. Ежегодно в этих странах регистрируется до 500 тысяч случаев заболевания, причем около 5 тысяч из зараженных умирают. Причиной смерти обычно оказывается несвоевременная помощь — при должном лечении, люди остаются в живых.

Крыса вида Mastomys
От животных к людям вирус передается через их отходы жизнедеятельности. Иногда человек незаметно для себя касается места, где гадили грызуны и не моет после этого руки. Во время еды вирус попадает в пищу, а потом оказывается внутри человеческого организма. От человека к человеку вирус Ласса тоже передается через фекалии и мочу, также были зафиксированы случаи заражения через половой контакт. Случаи распространения воздушно-капельным путем не зарегистрированы.
Читайте также: Как помыть руки, чтобы на них не осталось опасных бактерий?
Симптомы лихорадки Ласса
После заражения, болезнь проявляет свои симптомы в период от 6 до 21 дней. Сначала человек чувствует слабость и у него поднимается температура тела — это признак того, что вирус начал действовать и организм это заметил и пытается с ним справиться. Спустя несколько дней возникает головная боль, ломота в мышцах, диарея и кашель. При развитии осложнений у пациента опухает лицо, накапливается жидкость в легочных пазухах, течет кровь изо рта, носа и так далее. При крайней степени заболевания человек впадает в шоковое состояние и даже кому.

Лихорадка Ласса распространена в Западной Африке
Лечение лихорадки Ласса
Если говорить в целом, лихорадка Ласса поражает органы дыхания, центральную нервную систему и почки. Так как болезнь имеет симптомы, схожие с другими видами лихорадок, диагностировать ее трудно. Без использования специальных тестов, ее легко спутать с болезнью Эбола, малярией, брюшным тифом, желтой лихорадкой и так далее. Данные о летальности лихорадки Ласса разнятся: по данным ВОЗ, риск смерти равен всего лишь 1%, а другие источники гласят о гораздо более высоких показателях.
Лихорадку Ласса легко спутать с другими заболеваниями
Шансы на выживание многократно повышаются при раннем диагностировании. Вакцин против лихорадки Ласса не существует, потому что врачи просто назначают больным лекарства против вирусов. Примерно у 25% излечившихся развивается глухота, но у половины из этих людей слух восстанавливается спустя 1-3 месяца.
Читайте также: Ученые нашли у животных мутацию гена, которая блокирует размножение ВИЧ и вируса Эбола
Риск распространения лихорадки Ласса
Тот факт, что лихорадка Ласса была обнаружена в Великобритании, встревожил многих людей. Однако, учитывая способы его распространения, она не может стать причиной начала новой эпидемии. Зараженные люди помещаются на изоляцию, а контактирующие с ними врачи хорошо защищены. Учитывая очень низкую скорость распространения вируса Ласса, представители ВОЗ не считают его поводом для серьезных беспокойств.

Риск распространения лихорадки Ласса по всему миру очень мал
Если вам интересны новости науки и технологий, подпишитесь на наш Telegram-канал. Там вы найдете анонсы свежих новостей нашего сайта!
Но данный случай является очередным напоминанием о важности мытья рук. Жителям сельской местности стоит быть наиболее внимательными, потому что грызуны могут переносить множество других заболеваний. Например, на территории России можно подцепить «мышиную лихорадку», возбудителями которой являются сразу несколько видов вирусов.



Новости, статьи и анонсы публикаций
Чат с читателямиСвободное общение и обсуждение материалов